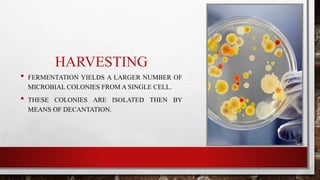
HARVESTING
• FERMENTATION YIELDS A LARGER NUMBER OF
MICROBIAL COLONIES FROM A SINGLE CELL.
• THESE COLONIES ARE ISOLATED THEN BY
MEANS OF DECANTATION.

This document discusses single cell proteins (SCP), which are dried cells from bacteria, algae, yeast, and fungi that are rich in protein. SCP can be produced from various waste materials and includes residues from orange peels, sugarcane, paper mills, wheat straw, sugar beets, coconuts, grapes, and mangos. The selection of microbe strain and substrate is crucial, choosing ones that do not produce toxins or harm consumers. SCP is produced through fermentation, harvesting, and processing to isolate pure protein while removing impurities. Advantages are high protein content and ability to modify production easily using various raw materials, while disadvantages include potential toxins, allergic reactions, and high costs